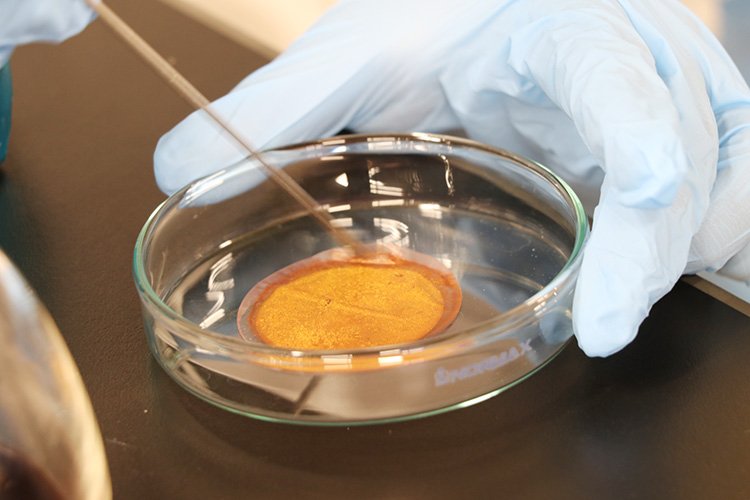

KANDAI
TOPICS日常の出来事

中学2、3年生と高校1、2年生を対象に毎年夏に開催される参加型プログラム「ひらめき☆ときめきサイエンス~ようこそ大学の研究室へ~KAKENHI」を、8月7日、千里山キャンパスで実施しました。本プログラムは、文部科学省による科学研究費助成事業(科研費)を元に大学などの研究機関で行われている最先端の研究成果の一端を「直に見る、聞く、触れる」ことで、中高生に科学のおもしろさを実感してもらうことを目的としています。6年目の採択となった今年も、環境都市工学部の村山憲弘教授が「資源循環工学の面白さを学ぼう(第6回)~廃棄物に新たな価値を見出そう!~」をテーマに、SDGsの目標12「つくる責任、つかう責任」 にかかわる資源リサイクルの重要性を伝えるべく講義や実験を企画しました。
当日は開講式とオリエンテーションを皮切りに、村山教授による講義「廃棄物に新たな価値を見出そう」と、大阪大学工学研究科の鈴木賢紀准教授による「廃棄物リサイクルの新しい考え方」をテーマにした招待講演を実施。環境に配慮した有価物の分離・回収や廃棄物の有効利用の考え方などについてやさしく解説しました。
ランチタイムはキャンパス内の生協食堂に移動し、昼食を取りながらの交流会。受講生とその保護者は村山研究室の4年次生や大学院生らと会話を交わし、大学食堂の雰囲気を楽しみました。
午後は、「水溶液から貴金属だけを固体粒子として回収する実験・実演」 と「水溶液から有害物を吸着除去する実験・実演」を行いました。金の固体 粒子の輝きや有機色素溶液の色の変化を実際に目で見た受講者からは、歓 声が上がりました。
クッキータイム(休憩時間)には、アイスクリームを片手に、研究室での過ごし方や科研費研究成果をわかりやすく解説したパネル展示を囲んで一休み。くつろいだ雰囲気のなか、受講者や保護者が質問し、学生・教員が丁寧に答えていました。
プログラムの修了式では、村山教授が受講者一人ひとりに「未来博士号」を授与。参加者した中高生からは、「大学の教室や実験室が素晴らしかったです」「大学の先生や学生とたくさん話ができて良かったです」「興味のあるリサイクルについて勉強や実験ができ、充実した一日になりました」など、さまざまな感想が寄せられました。
- ホーム
- 関西大学について
- 大学広報・プレスリリース
- トピックス 一覧
- トピックス 詳細